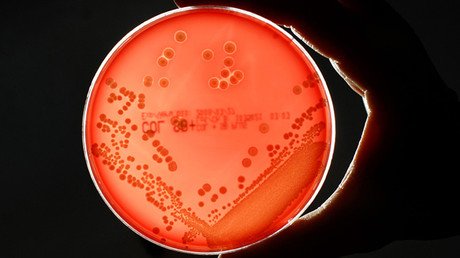
Hallan una insólita causa de enfermedades humanas

La extinción de ciertos microbios provocada por la actividad humana puede estar detrás de varias enfermedades físicas y mentales que sufren los humanos, según un grupo de científicos. Esta paulatina reducción de especies que coevolucionaron con nosotros puede estar relacionada con la aparición de una amplia gama de problemas de salud, incluida la obesidad, el asma, la enfermedad inflamatoria intestinal, la psoriasis e incluso varios trastornos psicológicos.
"La civilización ha reducido la diversidad de bacterias intestinales", constató Michael Gillings, de la Universidad de Macquarie (Australia) durante una reunión anual de la Sociedad Estadounidense de Microbiología, celebrada en Boston el domingo pasado. Gillings cree que esa disminución en la diversidad comenzó hace 350.000 años cuando los homínidos aprendieron a usar el fuego, recoge 'New Scientist'.
Desde que los humanos empezaron a alterar los ecosistemas en la Tierra, periodo conocido como Antropoceno, los microbios han estado en regresión: fundamentalmente aquellos que habitan nuestro cuerpo. Con la Revolución Industrial el proceso se agudizó.
La agricultura, las dietas, la higiene y generalización de los antibióticos son responsables de la reducción de la diversidad de microorganismos en el sistema digestivo humano, en especial en los países más desarrollados. En los últimos dos siglos y medio la aparición de los desinfectantes, el saneamiento, los alimentos procesados, los nacimientos por cesárea, la alimentación con biberón, los viajes internacionales, y, sobre todo, los antibióticos, ha dado lugar a una significativa pérdida de diversidad y homogeneización de las bacterias y otras especies que viven dentro de los seres humanos en todo el planeta.
"Parece que el microbioma tiene efectos específicos sobre la actividad cerebral y la ansiedad y la depresión han sido vinculadas con el síndrome del intestino irritable", afirmó Gillings.
Apocalipsis agrícola
La diversidad bacterial se redujo acusadamente hace unos 10.000 años, cuando los humanos inventaron la agricultura. La limitación de nuestras dietas afectó a nuestra flora intestinal. La agricultura también afectó los microbios que habitaban en otros animales. La crianza de ovejas, cerdos o aves de corral aumentó su proporción en la fauna global de la Tierra, reduciendo el hábitat de los microbios.
Gracias al tratamientro de la comida con fuego, nuestra especie logró obtener más calorías de los alimentos: como consecuencia nos ha crecido el tamaño del cerebro pero han disminuido los intestinos. "Cuánto más cortos son los intestinos, menos espacio hay para los microbios", explicó Gillings.
Hace unos 12.000 años la mayor parte de la microbiota intestinal- unas 200 millones de toneladas a escala global- vivía dentro de animales silvestres. En 2000 la proporción de microbios en animales salvajes ya era muy pequeña en comparación de los 600 millones de toneladas de microbios existentes en el ganado y los 200 millones que hallamos en los humanos. "Dado que consumimos solo cuatro especies de ganado, reducimos completamente la diversidad indispensable para remplazar nuestros genes cuando es necesario", recordó Antje Boetius, del Instituto de Microbiología Marítima de Bremen (Alemania).